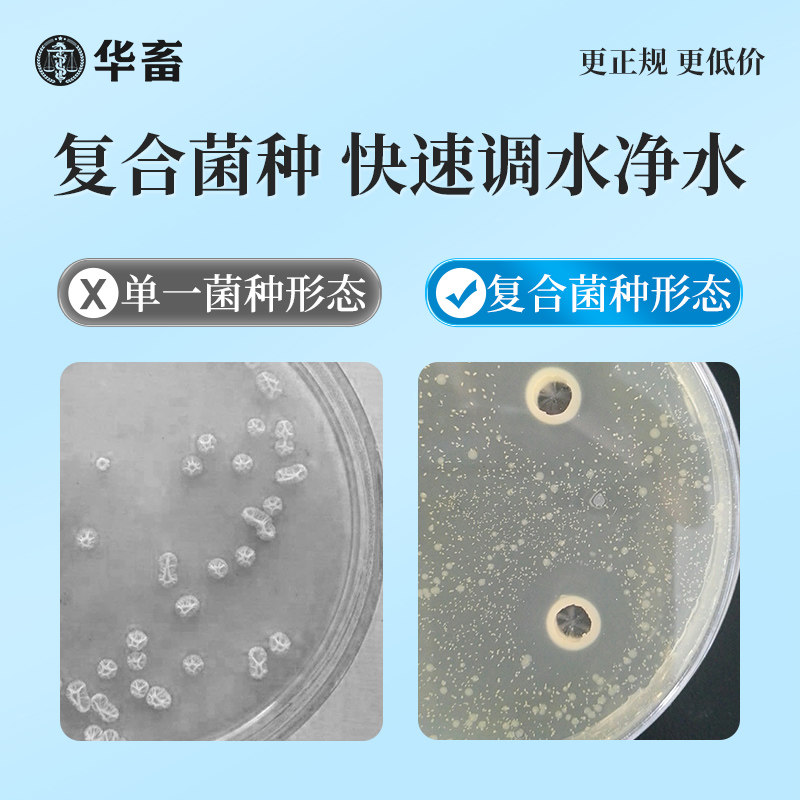
商品详情图片

华畜复合芽孢杆菌菌种水产养殖专用原种菌粉虾蟹鱼塘活菌em益生菌
华畜复合枯草芽孢杆菌水产养殖
¥8.60
¥10.36
17% OFF
商品ID:
y3eOdVz3fRt20v63ZmoHz3kFvtA-A9w6xVsKKnpO2gysYQ
分类:
宠物/宠物食品及用品
华畜旗舰店
淘宝店铺
商品详情